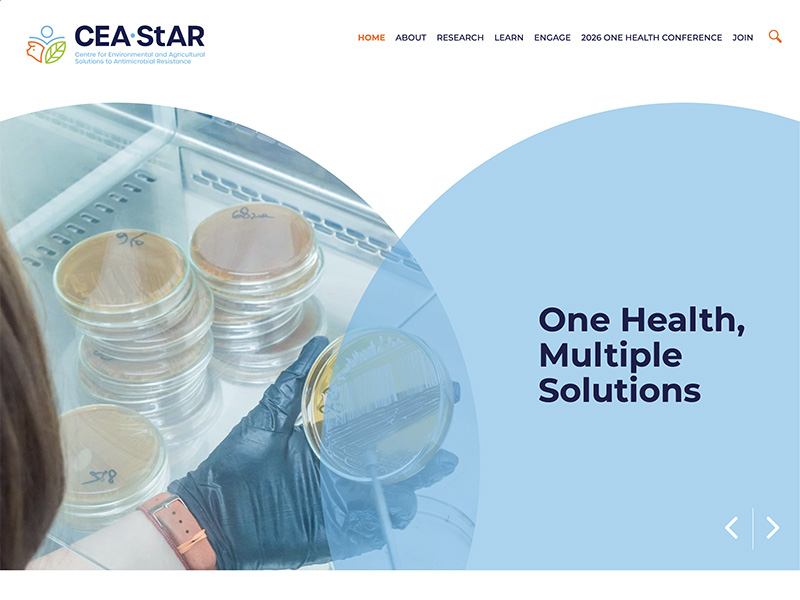

Business website.
Designed today.
Built today.
Live today!
Built by a 30+ year digital design expert (not Ai)
Whether you're a tradesperson, accountant, hairdresser or any business looking to get off to a meteoric start then a GoLive website designed, and built in a day is the perfect choice.
No long lead times, extended design sessions or large price tag, just a professionally designed and working website built by a digital design expert to get you trading immediately – all done in a single day.
























Custom designed for your business
Even though this is a rapid service this is no cheap template conversion, this is meticulous, experience driven professional website build from a 30+ year digital design veteran.
Efficient design and build means less cost
By completing the sitemap, wire-frame, design, and launch all in one day you have no waiting, no unnecessary delays and more importantly no unnecessary cost.
Built by an expert, easily updated by you
By partnering with Webflow we build your website to a high standard on super fast and secure servers that easily allow for future updates and modifications by you - no coding required.
The process is simple – we do it all, then you start trading.
9am – Tell us about your business
Share your business vision and requirements in a single conversation, setting the stage for the website direction.
10am – We map and sketch the structure
Sitemap and wire-frame take shape based on your business goals and are sent to you for approval.
1pm – Design comes to life on screen
Visual design and responsive layouts are crafted by design expert with care aimed at maximum conversion.
5pm – Your site goes live today
Deployment, testing, SEO and domain connection are completed so your business launches before the day ends.




Everything built in a single day
We manage everything from the initial concept to the final deployment. Each component is crafted with precision and launched while the day is still young.

Your site performs from day one
No waiting for improvements or fixes after launch. The work is complete, tested, and ready to work for you immediately.

Built fast without cutting corners
Speed and quality are not opposites here. We move quickly because we know exactly what we're doing, and we do it right.

One conversation, one price, one day
No complicated contracts or endless revisions. You tell us what you need, we design and build it, and its live that day.

Stand out in rapid time
Launched from concept to live – in one day

What you gain when you choose speed
Immediate results
Your website works the moment it launches. No beta testing. No gradual rollout.
Competitive edge
While others plan, you're already live and capturing customers in your market.
Clear investment
One price. One day. No hidden costs or surprise fees down the line.
Peace of mind
The work is finished. The site is live. You can focus on running your business.
From zero to online and trading in one day
Feedback
Our clients say about the quality, reliability, and speed that sets us apart.
FAQs
For additional information, please refer below .
The only additional fee is a monthly hosting fee of around $30 per month and a domain renewal fee every two years of around $50.
Absolutely, we use a system that makes it easy to make changes, add pages and images to website - no coding required. You will get your own access to the back end so you can make changes or we can help you out with content updates.
Yes, we will provide relative content and images to ensure the site is launched ready to appeal to customers. You can also log in and modify this content any time in the future.
Yes, we will do on page optimisation to help your site rank and be indexed by Google.
Yes Webflow our site builder is built for AI optimisation. Be assured your site is fully ready trade compete and succeed.
Book now
Never been a better time to get your business up and running.
Book your initial meeting now to start the process.
